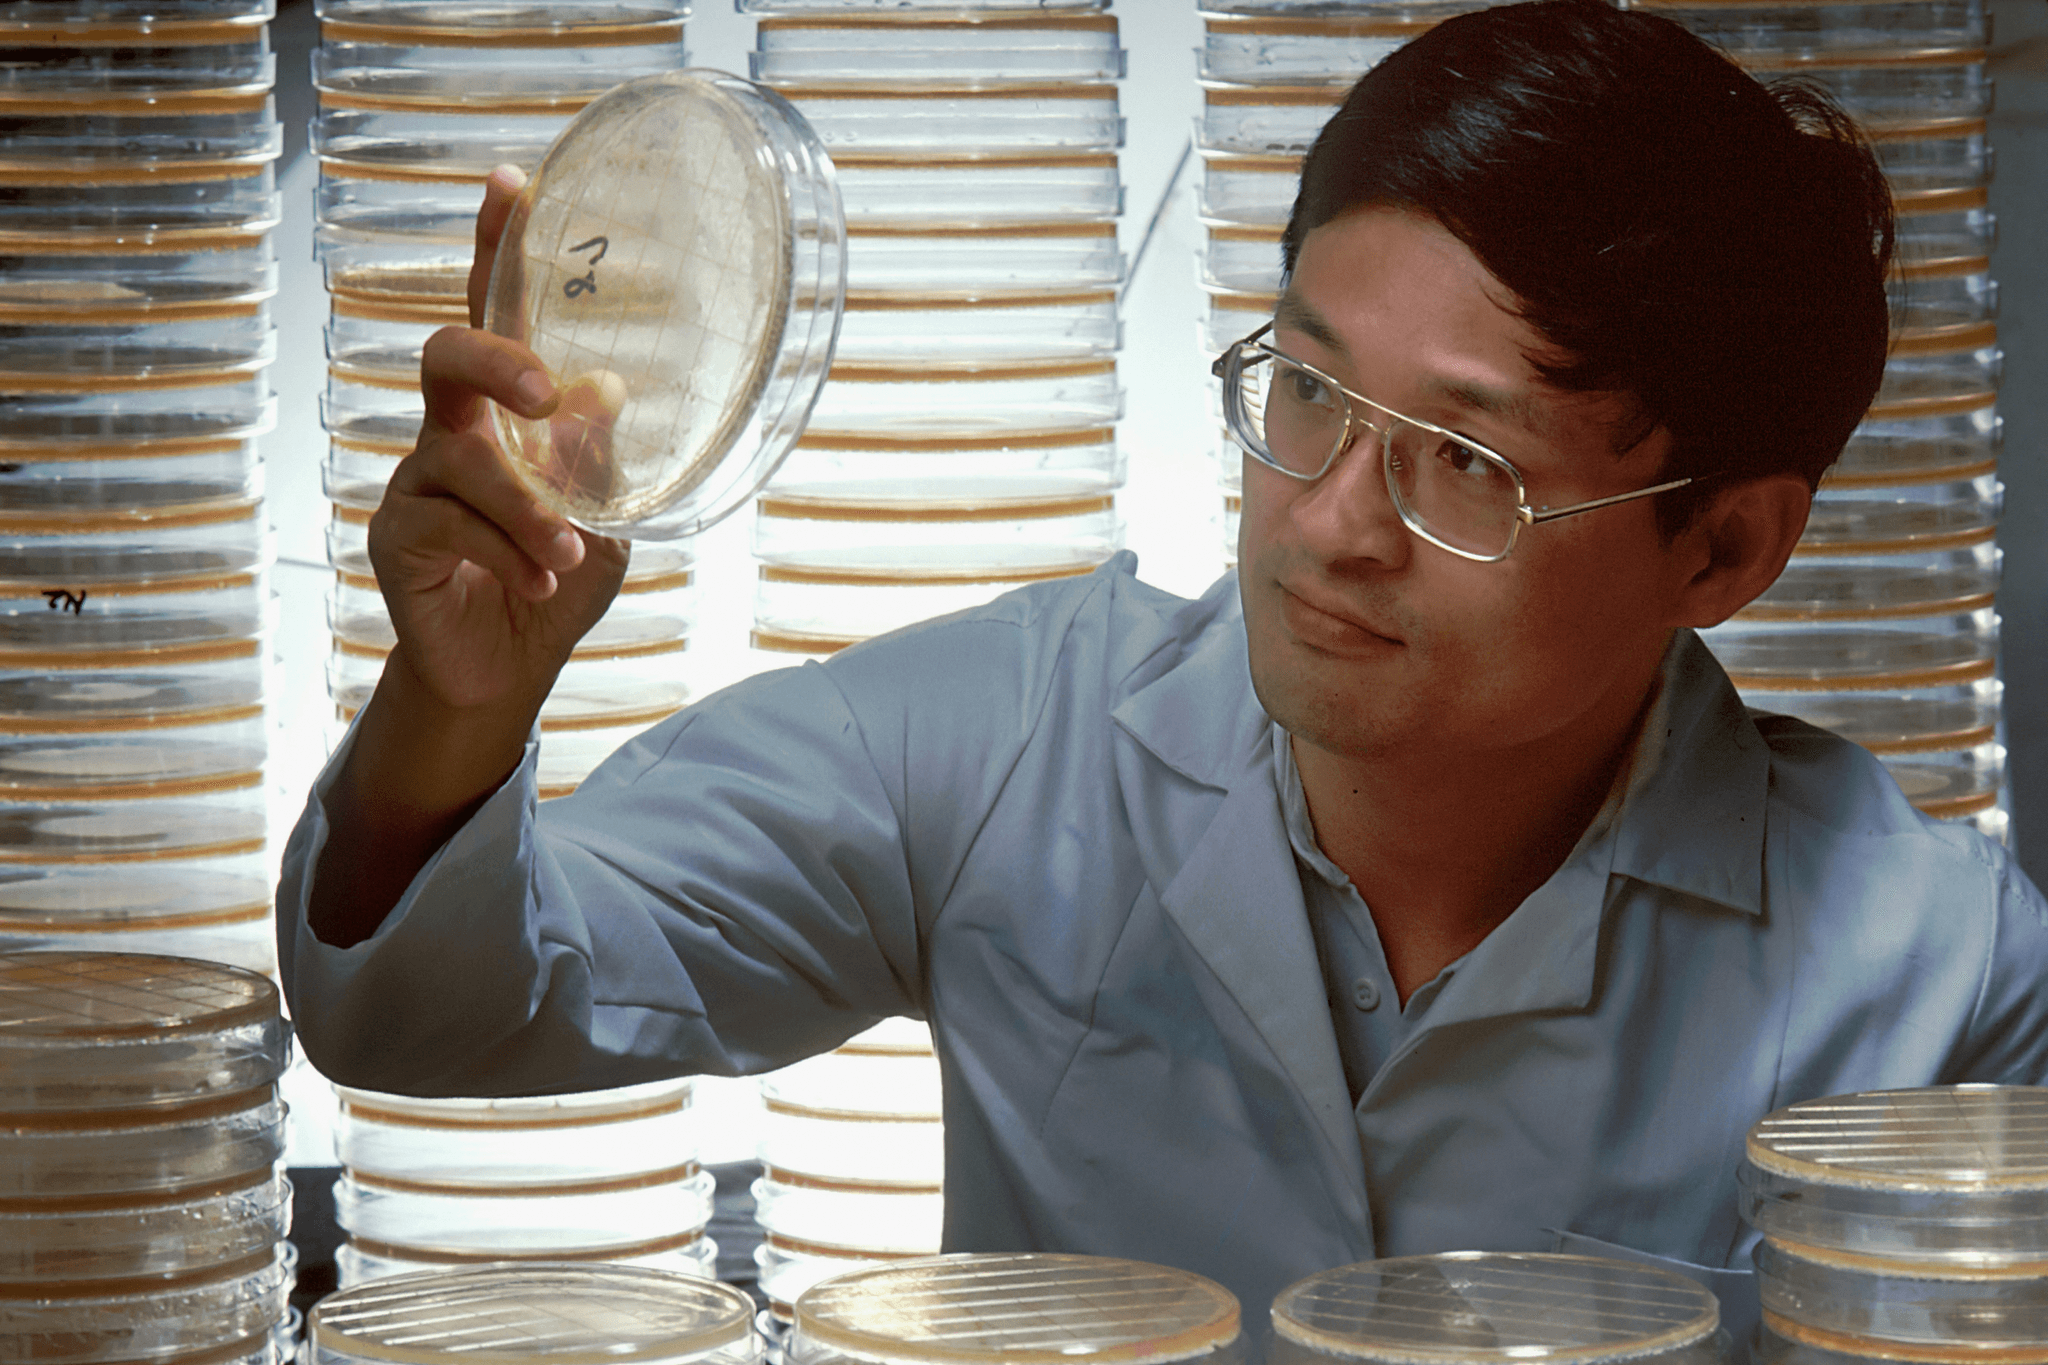
Section image

ESTHER BEAUTY 依絲緹美/依絲神泌 系列
重組細胞自癒美容新密碼
外在美的關鍵是肌膚細胞活性,而最佳解決細胞活性問題的方法,就要回到細胞本身的運作機制去尋求答案。
Extracellular Vesicles, EVs,泛稱胞外體,其中也包含動物性來源的外泌體(Exosomes),以及非動物性來源的相同結構胞外小體,
不同的胞外體相互進行協同作用,在細胞與細胞間做為組織再生修復的通訊運輸信使。
胞外體不只動物有,所有多細胞生物都會產生,胞外體的挹注與補充,除了運用在美容領域,也已在醫療與醫美的應用上引發關注。

【產品研製原廠】非動物性外泌體培製專家:
沛泉生醫-領航靈芝胞外小體新科技
沛泉生醫由熟悉新藥開發與生技產業脈動的專家學者所成立,招募的核心研發團隊中,包含多位外泌體博士級專家與高階技術科學家,
團隊擁有數十篇文獻與專利支持,形成建立「功效型植物外泌體樣品庫」以及「醫藥級植物外泌體功效篩選平台」最堅實的後盾。
【產品開發與製造】
沛泉生醫通過先進的生物技術和生產設施,致力於研發和製造創新的生醫產品,包括藥品、保健品和化妝品等。
【生物技術研究】
沛泉生醫科研團隊致力於生物技術領域的前沿研究,包括基因工程、細胞培養、蛋白表達等,以開發出更有效的治療方案和產品。
【臨床試驗與驗證】
沛泉生醫與醫療機構合作,進行臨床試驗和驗證,確保產品符合安全、有效的標準,並獲得相應的認證。
【社會責任與公益活動】
沛泉生醫積極參與社會責任和公益活動,回饋社會,關愛社區,促進健康事業的發展和進步,以實現企業的可持續發展和社會價值的最大化。
https://www.exoverabiomed.com/
非動物/非植物 靈芝真菌蕈菇-化腐朽為神奇!
解鎖千年神秘靈芝胞外小體應用機制
●首家以非動物性外泌體為開發核心的生技培製廠
●國內知名美妝品牌靈芝精華外泌體原料供應
●美日歐盟核准之美容化妝品原料
●獨家外泌體純化技術-膜化增效製程
●真菌/蕈菇蛋白外泌體的獨家領導生技廠
科研團隊持續探索靈芝胞外小體的潛在功效,並在其基礎上開發出多款創新產品,為消費者提供最佳醫療、美容方案。。研發實力
堅實的學術與醫療支持,為我們的產品保駕護航。

專利與技術能力(持續增加中)
我們與多所知名大學及研究機構合作,確保產品的科學性與有效性。
美日歐盟認證(局部露出)
於化妝品原料市場進行全球性布局,除了美國、日本、歐盟之外,其他主要國家區域之專利與認證也逐步進行中。

文獻支持(局部露出)
至少三十多篇世界專業期刊發表的研究報告,支持小孢子靈芝胞外小體的應用理論及其功效。
專業背書
我們的團隊由頂尖專家組成,致力於提供最安全、有效的產品。
科研顧問團隊
我們的科研顧問團隊包含多位在再生醫學領域有卓越成就的專家,為產品的研發提供專業指導。
醫師支持
我們的產品經過多位專家及美業醫師的評估和背書,保證其安全性和有效性,讓您使用無憂。

精益求精
我們重視團隊成員的持續教育,定期參加國際會議,保持對最新研究的了解,以推動產品創新。
©2025 - Goai8.me 製作